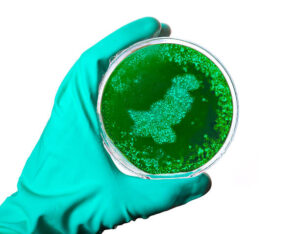
The Pakistani Petri Dish

Welcome to Jarida Today, a premier newspaper that strives to be the vanguard of quality journalism. With a focus on development and cultural diversity, we are dedicated to informing, inspiring, and engaging our readers while offering a balanced perspective. As enshrined in Article 19 of Pakistan’s Constitution, Jarida Today upholds the right to freedom of expression.
Publisher
Mr. Jairus Ben Jesus
CEO
Ch. Ghulam Mujtaba Murala
Know Us Better
Special
Categories
Contact Detail
- 120-D, Business Hub, Broadway Commercial, Phase-VIII, Defense Housing Authority, Lahore, 54000, Punjab, Pakistan
- +92 346 6582 352
- jaridaeditorial@gmail.com